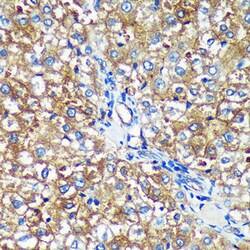

Promotional price valid on web orders only. Your contract pricing may differ. Interested in signing up for a dedicated account number?
Learn More
Learn More
Invitrogen™ PYCR2 Polyclonal Antibody


Rabbit Polyclonal Antibody
Supplier: Invitrogen™ PA590260
Description
Immunogen sequence: MADQEKISPA ALKKTLLDRV KLESPTVSTL TPSSPGKLLT RSLALGGKKD; Positive Samples: HeLa, A-431, HT-29, Mouse brain, Rat testis; Cellular Location: Cytoplasm, Mitochondrion.
PYCR2 belongs to the pyrroline-5-carboxylate reductase family. The function of the PYCR2 protein is not known.
Specifications
| PYCR2 | |
| Polyclonal | |
| Unconjugated | |
| Pycr2 | |
| 1810018M05Rik; HLD10; P5C reductase 2; P5CR 2; P5CR2; Pycr2; pyrroline 5-carboxylate reductase isoform; pyrroline-5-carboxylate reductase 2; pyrroline-5-carboxylate reductase family member 2; pyrroline-5-carboxylate reductase family, member 2; QtsA-16987; unnamed protein product | |
| Rabbit | |
| Affinity chromatography | |
| RUO | |
| 29920, 364064, 69051 | |
| -20°C, Avoid Freeze/Thaw Cycles | |
| Liquid |
| ELISA, Immunohistochemistry (Paraffin), Western Blot, Immunocytochemistry | |
| 0.84 mg/mL | |
| PBS with 50% glycerol and 0.05% ProClin 300; pH 7.3 | |
| Q6AY23, Q922Q4, Q96C36 | |
| Pycr2 | |
| Recombinant fusion protein containing a sequence corresponding to amino acids 271-320 of human PYCR2 (NP_0374602). | |
| 100 μL | |
| Primary | |
| Human, Mouse, Rat | |
| Antibody | |
| IgG |
Product Content Correction
Your input is important to us. Please complete this form to provide feedback related to the content on this product.
Product Title
Spot an opportunity for improvement?Share a Content Correction